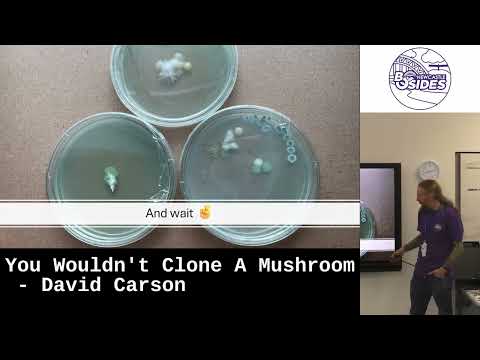
YouTube video

Ben the Pyro Guy @pyroguy-uk.bsky.social retweetledi

Mission Transmissions Continue: 3D Printing, Innit by Ben Docherty.
Strap in, cadets!
Join Ben as he charts his interstellar journey through the galaxies of 3D printing. Expect stellar tips to avoid system failures and keep your prints orbit-perfect.
youtu.be/0tSSeVFCiUo

YouTube

English